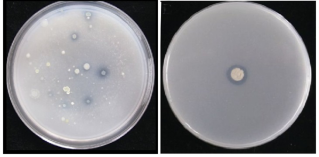
解磷菌无机磷固体培养基/pvk固体培养基 北京酷来搏科技有限公司

无机磷

无机磷质(inorganic phosphate)
图片尺寸500x441
血清无机磷 phosphorus
图片尺寸900x507
优质三溴氧磷 厂家直销
图片尺寸350x583
过磷酸钙园艺花肥无机磷肥花卉蔬菜花化肥料纯磷肥不含氮
图片尺寸800x800
无机磷培养基不含琼脂测磷细菌解磷效能
图片尺寸1000x1239
过磷酸钙 园艺花肥 无机磷肥 花卉蔬菜花化肥料 纯磷肥不含氮_双氙
图片尺寸640x853
无机磷几乎都以各种磷酸盐形式存在,包括正磷酸盐,偏磷酸盐,磷酸氢盐
图片尺寸741x750
土壤无机磷(s-phos)含量检测试剂盒
图片尺寸800x800
水处理专项污染物处理之无机磷篇
图片尺寸497x357
无机磷的测定ppt
图片尺寸800x600
磷的分类及性质
图片尺寸550x231
无机磷的测定ppt
图片尺寸800x600
【水处理】专项污染物处理之无机磷篇
图片尺寸496x354
次磷酸铝 cas:7784-22-7 工业级 次磷酸铝盐 新型无机磷系阻燃剂多聚
图片尺寸750x750
介绍如下: (一)产品用途,机理及特点:我司的脱磷剂主要用于去除无机磷
图片尺寸740x503
无机磷解磷菌的透明圈问题
图片尺寸450x800
由"有机磷和无机磷"一节总结可知:无机磷主要来源于含磷添加剂,存在于
图片尺寸640x426
总磷和有机磷和无机磷的区别(图)
图片尺寸556x309
细菌等;3,分解土壤中难溶性矿物的菌肥:包括硅酸盐细菌,无机磷细菌等
图片尺寸640x929
解磷菌无机磷固体培养基/pvk固体培养基 北京酷来搏科技有限公司
图片尺寸319x157